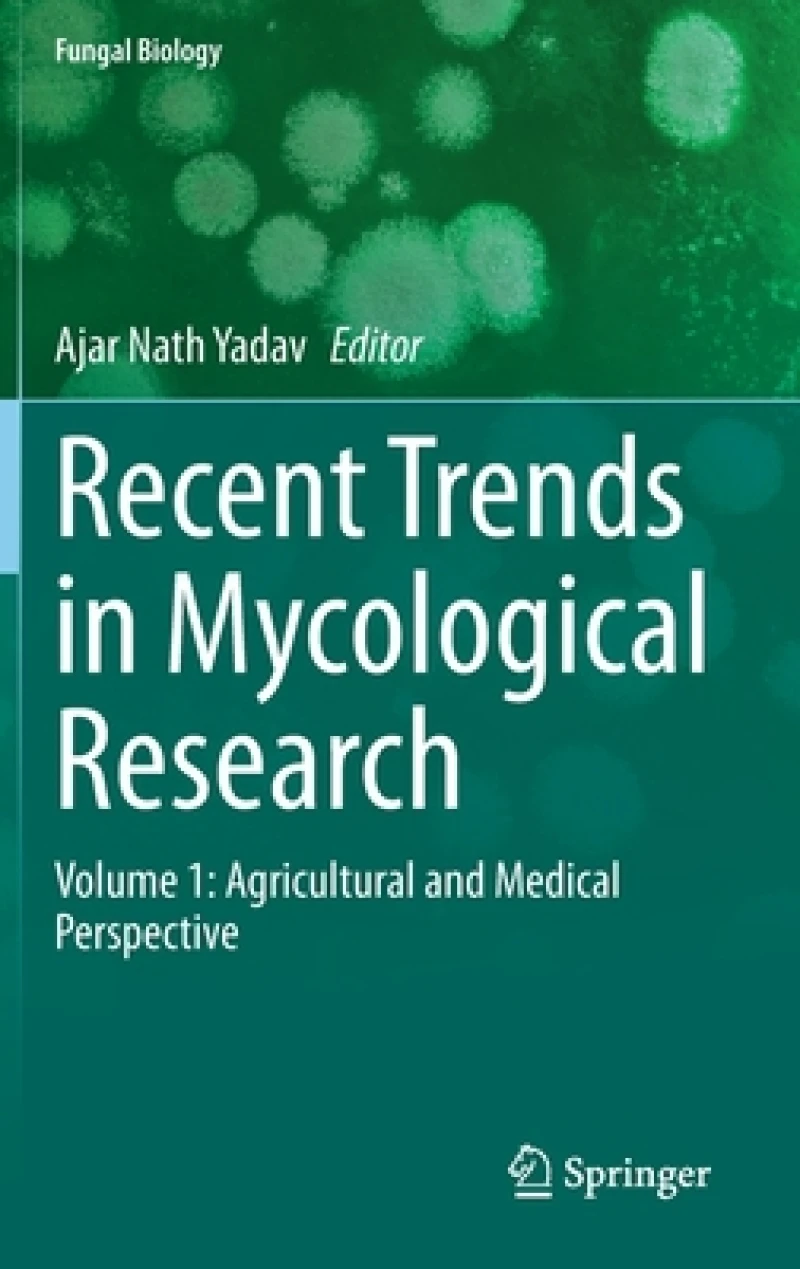
Recent Trends in Mycological Research

Series: Fungal Biology
Discover stories that captivate and knowledge that empowers. Your next great read is waiting.
Showing 21 of 21 titles
Showing 21 of 21 titles
Looking for something else?
Deep Search (Show All Results)
Welcome to Werezi Books
Your one-stop shop for all reading needs. Bestsellers, local titles, and academic texts.